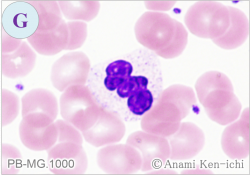

ロシアによるウクライナへの軍事侵攻から1年が過ぎ、先のみえない不安の日々が続いています。この非常事態を払拭するかのように2023年3月4日、福岡県の東部に位置する行橋市のJR行橋駅前に戦争終結と平和を願う銅像が立ちました。
行橋市の国際彫刻展で大賞に選ばれたウクライナの彫刻家、ウォロディミル・コチュマルさん(52歳)が制作された高さ2mのブロンズ像です。コチュマルさんはウクライナ東部の在住で、2022年2月に行橋市などが催す国際公募彫刻展に応募したのですが、その直後にロシアの侵攻が始まり、ウクライナは戦火に包まれ、コチュマルさんの住むハルキウも激戦地となりました。制作は困難を極め、審査のための作品模型を行橋市に届けることができたのは審査の当日、国内外から応募された44作品のなかから見事大賞に選ばれたのです。大賞の作品は街に飾られるため、実物のブロンズ像にしなければなりません。ウクライナでの制作が困難となったコチュマルさんに手を差し伸べたのは富山県高岡市の工房梶原製作所さんで、コチュマルさんは去年11月に来日し無事に作品を完成するに至りました。
そのモチーフになったのは、メキシコの女性画家フリーダ・カーロさんです。カーロさんは、病気や事故の後遺症といった困難の中で絵筆を握り、不屈の精神で名作を残した女性といわれます。報道インタビューで、コチュマルさんは「信じられないことです。喜びを言い表せません。制作に協力してくれた高岡市の皆さんの愛情によりこの作品ができました。また、戦争の中で、ウクライナの郵便局から銅像を送ることはとても大変でした。爆撃の中で、ミニチュアの銅像を作り、日本に送るのを手伝ってくれた友人に感謝しています」と、また支援された梶原製作所の梶原寿治社長は「彼が制作期間の間だけでも、大変な環境を忘れて没頭してくれたのがうれしい」と述べられています。
コチュマルさんは、五年前に石像の制作のために行橋市に滞在したこともあり、地元の人からは手作りのプレゼントがなされたようです。コチュマルさんは、「彼女は決してあきらめてはならないことを教えています。誰かが困難に直面した時には、サポートして支えるようにして欲しいです。そして愛と平和が、皆さまとともにありますように」と結んでいます。
フリーダ・カーロさんの姿と母国ウクライナの人々を重ね合わせ、ウクライナが1日でも早く平和を取り戻すことをカーロさんも力強く見守っているのです。

JR行橋市駅前に立つフリーダ・カーロさん
(メキシコ女性画家)のブロンズ像

JR行橋駅前広場
(撮影.H.EMIKOさん.2023.3.11)

「ウクライナの終戦、世界の平和を祈る!」
制作者:ウオロデイミル・コチュマ氏
(ウクライナ彫刻家)

2023年4月号の問題. 下記のご質問をいただきましたがどのようにお答えしますか。
| 【疑問】 | 末梢血の異型リンパ球のカウント数が技師間で異なり困っています。基準を一定にするための方法があれば教えてください。 併せて末梢血で異常リンパ球をみつけるポイントを教えてください。 |
|
2023年4月号の解説.
| 【提言1】 | まず異型リンパ球(反応性リンパ球)はウイルス感染症などで末梢血にみられますが、リンパ球に何らかの抗原刺激が加わった際の変化像とみなされ、その変化像とは、多彩様式をとり、細胞が大きくなったり、細胞質が好塩基性を帯びることです。多彩とは単球様、形質細胞様、(リンパ)芽球様が混在することで、大きさについては16μm以上を目安(JSLH.2003)に、好塩基性については細胞質全体もしくは部分的また放射状に青色を呈することに着目します。大きさの概算は、赤血球の大きさ(7~8μm)から算出することや接眼レンズにセルメーター(cell meter)を挿入して計測する方法があります。表1.表2.に私見を含め述べます。 |
| 【目線の統一に向けて】 | 異型リンパ球の形態所見を参考にして、目合わせのための反復鏡検を重ね観察者による目線の統一策を講じます。類似細胞(大リンパ球・異常リンパ球・単球)との鑑別は不可欠になります。 |
表1. 異型リンパ球の条件
|
表2. 異型リンパ球の判定評価
|
|||
![]() |
|
||
| 【提言2】 | 次に末梢血における「異常リンパ球」の鑑別ポイントについて私見を含めて述べます。異常リンパ球は腫瘍細胞と認識しますが、鑑別細胞はリンパ球や異型リンパ球になります。異常リンパ球の条件として表3.に、その条件をポイント制にしたものを表4.に示します。単一様式は必須条件で、関連疾患では3 ポイント以上を呈する症例が多いようです。 核質の状況を理解するために、核を四分割すると緻密さや染色性を捉えることができます(大久保ら.2002)。核の四分割法については、画像の異常リンパ球(A)と異型リンパ球(E)を参考に比較してみてください。 |
![]() |
表3. 表3.異常リンパ球の条件
|
||
表4. 異常リンパ球の条件からみるポイント制
|
|

2023年5月号の問題. 下記のご質問をいただきましたがどのようにお答えしますか。
| 【疑問】 | ペルゲル(様)核異常の好中球はotherとして報告するというお話でしたが、その場合、化学療法などの基準とされる好中球数にはこれらの形態異常の好中球は含めないのでしょうか、それとも合算してもよいのでしょうか。 また、システム的に絶対数は再計算されて報告されているのでしょうか。 |
|

形態マガジン号キャプテン 阿南 建一

4月より血液室に配属された皆さまもいらっしゃいますので、今回は末梢血液像に挑戦してみたいと思います。末梢血液像は形態診断の第一歩でもあり見逃しは決して許されませんので同定を行ってみてください。
新規の「ワンポイントアドバイス」は、ペルゲル(様)核異常の好中球を取り上げましたので皆様のご意見を賜りたいと思います。
問題1
PB-MG.1000

PB-MG.1000

PB-MG.1000

PB-MG.1000

PB-MG.1000

PB-MG.1000

PB-MG.1000
PB-MG.1000

PB-MG.1000

問題 1
末梢血液像の細胞同定を行ってください。
末梢血液像に挑戦してみたいと思います。細胞の大きさは回りの赤血球の大きさ(7~8µm)を参考にして下さい。D.とF.の顆粒球の核幅による判定基準は小宮法(1988)を参考にしています。
【正答】
A.単球 B.好塩基球 C.単球 D.後骨髄球 E.裸核 F.桿状核球 G.分葉核球 H.病的な前骨髄球
【解説】

A. 直径17μm大、上・下辺部が赤血球に押された感があるため実際はもう少し大きくなりそうです。核形不整が顕著でクロマチンは繊細、灰青色の細胞質には多くの空胞を認めることから単球と思われます。

B. 直径14μm大、核は分葉傾向ですが核縁は不鮮明で、細胞質には紫褐色の粗大顆粒(1μmほど)が核の上にも存在し、その一部は水溶性の性質によって顆粒が溶出したものとして好塩基球にしました。

C. 直径18μm大、核は類円形で軽度の不整、クロマチンはやや粗剛、豊富な細胞質は淡青色で微細顆粒が充満しています。核質はリンパ球に類似していますが、核形不整と微細顆粒を有することから単球にしました。

D. 直径15μm大、核は陥没し核幅の短径が長径の1/3以上でクロマチンがやや粗剛から後骨髄球としました。私見として核の片側陥没が1μmであることから後骨髄球としました。

E. 直径不明、標本塗抹時に細胞質が壊れ核のみが残存したもので核影(スマッジ細胞、グンプレヒトの核影、バスケット細胞)と呼ばれます。細胞として不成立ですので白血球分類には算定せず、100~200個中の個数を記載してもよいですが、アルブミン処理して塗抹標本を作成し直すことが大事です。

F. 直径14μm大、核はバナナ状を呈し核幅の短径が長径の1/3未満でクロマチンが粗大粗剛(一部結節)を認めることから桿状核球としました。私見として核の片側陥没が1μm以上であることから桿状核球としました。

G.直径13μm大、核はねじれ(濡れタオルを絞った様)でクロマチンは強度の結節状、細胞質は橙黄色で少数の顆粒は二次顆粒とみなし分葉核球と思われます。

H. 直径21µm大、N/C比はやや高く、核形不整がみられクロマチンは粗網状、細胞質は軽度好塩基性でアウエル小体の束状(矢印)を認めることから病的な前骨髄球と思われます。本例は急性前骨髄球性白血病の症例で、末梢血では見逃し禁止の細胞になりますので全視野の確認が必要です。

I. 直径14μm大、核はねじれ3分葉あたり、細胞質は橙紅色であることから好酸球と思われます。
これから先のページでは、医療関係者の方々を対象に医療機器・体外診断薬等の製品に関する情報を提供しております。当社製品を適正に使用していただくことを目的としており、一部の情報では専門的な用語を使用しております。
一般の方への情報提供を目的としたものではありませんので、ご了承ください。
医療関係者の方は、次のページへお進みください。
(お手数ですが、「進む」ボタンのクリックをお願いします)